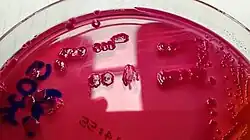

Phytobacter
| Phytobacter | |
|---|---|
| |
| Colonies of P. diazotrophicus on MacConkey agar. | |
| Scientific classification | |
| Domain: | Bacteria |
| Kingdom: | Pseudomonadati |
| Phylum: | Pseudomonadota |
| Class: | Gammaproteobacteria |
| Order: | Enterobacterales |
| Family: | Enterobacteriaceae |
| Genus: | Phytobacter Zhang et al. 2008 |
| Type species | |
| Phytobacter diazotrophicus | |
| Species | |
|
P. diazotrophicus | |
Phytobacter is a genus of Gram-negative bacteria emerging from the grouping of isolates previously assigned to various genera of the family Enterobacteriaceae. This genus was first established on the basis of nitrogen fixing isolates from wild rice in China,[1] but also includes a number of isolates obtained during a 2013 multi-state sepsis outbreak in Brazil[2][3] and, retrospectively, several clinical strains isolated in the 1970s in the United States that are still available in culture collections, which originally were grouped into Brenner's Biotype XII of the Erwinia herbicola-Enterobacter agglomerans-Complex (EEC).[4][5] Standard biochemical evaluation panels are lacking Phytobacter spp. from their database, thus often leading to misidentifications with other Enterobacterales species, especially Pantoea agglomerans.[2] Clinical isolates of the species have been identified as an important source of extended-spectrum β-lactamase and carbapenem-resistance genes, which are usually mediated by genetic mobile elements. Strong protection of co-infecting sensitive bacteria has also been reported.[6] Bacteria belonging to this genus are not pigmented, chemoorganotrophic and able to fix nitrogen. They are lactose fermenting, cytochrome-oxidase negative and catalase positive. Glucose is fermented with the production of gas. Colonies growing on MacConkey agar (MAC) are circular, convex and smooth with non-entire margins and a usually elevated center. Three species are currently validly included in the genus Phytobacter,[2][7] which is still included within the Kosakonia clade in the lately reviewed family of Enterobacteriaceae.[8] The incorporation of a fourth species, Phytobacter massiliensis, has recently been proposed via the unification of the genera Metakosakonia and Phytobacter.[9]
History
First described as Bacillus agglomerans in 1888 by M. W. Beijerinck[10] and later reclassified by Ewing and Fife as Enterobacter agglomerans,[11] the EEC has a history of many names changes and taxonomy updates that follows the evolution of taxonomy tools. In 1984, Brenner and coworkers, using DNA-DNA hybridization test, divided the EEC into thirtheen DNA relatedness groups (Biotypes), numbered from I to XIII.[12] In 1989, Françoise Gavini and coworkers proposed to rename Enterobacter agglomerans (previously included in Biotypes I and XIII) as Pantoea agglomerans,[11] while the genus Phytobacter emerged from the characterization of Biotype XII.[2]
Species
- Phytobacter diazotrophicus is the most common Phytobacter species recovered from the environment and humans and is an opportunistic pathogen associated with contaminated catheters or the use of total parenteral nutrition.[2][4]
- Phytobacter ursingii can biochemically be differentiated from Phytobacter diazotrophicus on the basis of its ability to metabolize d-serine and l-sorbose. Despite the presence of nitrogen-fixation genes suggests an environmental origin, only clinical isolates of the species have been reported so far.[2]
- Phytobacter palmae is a species with high nitrogen fixing ability that was first identified in Singapore in leaf tissues of oil palm (Elaeis guineensis).[7]
- Phytobacter massiliensis, whose type strain JC163T was isolated from the fecal flora of a healthy Senegalese patient and does not possess nitrogen-fixation genes.[9][13]
References
- ↑ Zhang, Guo Xia; Peng, Gui Xiang; Wang, En Tao; Yan, Hui; Yuan, Qing Hua; Zhang, Wu; Lou, Xu; Wu, Hui; Tan, Zhi Yuan (May 2008). "Diverse endophytic nitrogen-fixing bacteria isolated from wild rice Oryza rufipogon and description of Phytobacter diazotrophicus gen. nov. sp. nov". Archives of Microbiology. 189 (5): 431–439. doi:10.1007/s00203-007-0333-7. PMID 18060384. S2CID 27236264.
- 1 2 3 4 5 6 Pillonetto, Marcelo; Arend, Lavinia N.; Faoro, Helisson; D’Espindula, Helena R.S.; Blom, Jochen; Smits, Theo H.M.; Mira, Marcelo T.; Rezzonico, Fabio (2017-11-10). "Emended description of the genus Phytobacter, its type species Phytobacter diazotrophicus (Zhang 2008) and description of Phytobacter ursingii sp. nov". International Journal of Systematic and Evolutionary Microbiology. [Epub ahead of print] (1): 176–184. doi:10.1099/ijsem.0.002477. PMID 29125457.
- ↑ Pillonetto, Marcelo; Arend, Lavinia; Gomes, Suzie M. T.; Oliveira, Marluce A. A.; Timm, Loeci N.; Martins, Andreza F.; Barth, Afonso L.; Mazzetti, Alana; Hersemann, Lena; Smits, Theo H. M.; Mira, Marcelo T. (2018-08-13). "Molecular investigation of isolates from a multistate polymicrobial outbreak associated with contaminated total parenteral nutrition in Brazil". BMC Infectious Diseases. 18 (1): 397. doi:10.1186/s12879-018-3287-2. ISSN 1471-2334. PMC 6090600. PMID 30103698.
- 1 2 Rezzonico, Fabio; Smits, Theo HM; Montesinos, Emilio; Frey, Jürg E.; Duffy, Brion (2009-01-01). "Genotypic comparison of Pantoea agglomerans plant and clinical strains". BMC Microbiology. 9: 204. doi:10.1186/1471-2180-9-204. ISSN 1471-2180. PMC 2764716. PMID 19772624.
- ↑ Brenner, Don J.; Fanning, G. Richard; Leete Knutson, Jean K.; Steigerwalt, Arnold G.; Krichevsky, Micah I. (1984). "Attempts to Classify Herbicola Group-Enterobacter agglomerans Strains by Deoxyribonucleic Acid Hybridization and Phenotypic Tests". International Journal of Systematic and Evolutionary Microbiology. 34 (1): 45–55. doi:10.1099/00207713-34-1-45. ISSN 1466-5026.
- ↑ Zhang, Zhao; Li, Daixi; Shi, Xing; Zhai, Yao; Guo, Yatao; Zheng, Yali; Zhao, Lili; He, Yukun; Chen, Yusheng; Wang, Zhanwei; Su, Jianrong (2020-04-15). "Genomic characterization of an emerging Enterobacteriaceae species: the first case of co-infection with a typical pathogen in a human patient". BMC Genomics. 21 (1): 297. doi:10.1186/s12864-020-6720-z. ISSN 1471-2164. PMC 7156906. PMID 32293254.
- 1 2 Madhaiyan, Munusamy; Saravanan, Venkatakrishnan Sivaraj; Blom, Jochen; Smits, Theo H. M.; Rezzonico, Fabio; Kim, Soo-Jin; Weon, Hang-Yeon; Kwon, Soon-Wo; Whitman, William B.; Ji, Lianghui (2020-02-01). "Phytobacter palmae sp. nov., a novel endophytic, N2 fixing, plant growth promoting Gammaproteobacterium isolated from oil palm (Elaeis guineensis Jacq.)". International Journal of Systematic and Evolutionary Microbiology. 70 (2): 841–848. doi:10.1099/ijsem.0.003834. ISSN 1466-5026. PMID 31829916.
- ↑ Alnajar, Seema; Gupta, Radhey S. (2017-10-01). "Phylogenomics and comparative genomic studies delineate six main clades within the family Enterobacteriaceae and support the reclassification of several polyphyletic members of the family". Infection, Genetics and Evolution. 54: 108–127. doi:10.1016/j.meegid.2017.06.024. ISSN 1567-1348. PMID 28658607.
- 1 2 Ma, Yuanyuan; Yao, Rong; Li, Yuanyuan; Wu, Xiuqin; Li, Shuying; An, Qianli (2020-04-30). "Proposal for Unification of the Genus Metakosakonia and the Genus Phytobacter to a Single Genus Phytobacter and Reclassification of Metakosakonia massiliensis as Phytobacter massiliensis comb. nov". Current Microbiology. 77 (8): 1945–1954. doi:10.1007/s00284-020-02004-4. ISSN 1432-0991. PMID 32350604. S2CID 216650629.
- ↑ Edwards, Jane; Baque, Ellen; Tang, Jane (2004-11-01). "Proposal to acknowledge Beijerinck as the original author of the species Pantoea agglomerans. Request for an Opinion". International Journal of Systematic and Evolutionary Microbiology. 54 (6): 2437. doi:10.1099/ijs.0.02955-0. ISSN 1466-5026. PMID 15545493.
- 1 2 Gavini, F.; Mergaert, J.; Beji, A.; Mielcarek, C.; Izard, D.; Kersters, K.; De Ley, J. (1989-07-01). "Transfer of Enterobacter agglomerans (Beijerinck 1888) Ewing and Fife 1972 to Pantoea gen. nov. as Pantoea agglomerans comb. nov. and Description of Pantoea dispersa sp. nov". International Journal of Systematic Bacteriology. 39 (3): 337–345. doi:10.1099/00207713-39-3-337. ISSN 0020-7713.
- ↑ Brenner, D. J.; Fanning, G. R.; Leete Knutson, J. K.; Steigerwalt, A. G.; Krichevsky, M. I. (1984-01-01). "Attempts to Classify Herbicola Group-Enterobacter agglomerans Strains by Deoxyribonucleic Acid Hybridization and Phenotypic Tests". International Journal of Systematic Bacteriology. 34 (1): 45–55. doi:10.1099/00207713-34-1-45. ISSN 0020-7713.
- ↑ Lagier, Jean-Christophe; El Karkouri, Khalid; Mishra, Ajay Kumar; Robert, Catherine; Raoult, Didier; Fournier, Pierre-Edouard (2013-02-22). "Non contiguous-finished genome sequence and description of Enterobacter massiliensis sp. nov". Standards in Genomic Sciences. 7 (3): 399–412. doi:10.4056/sigs.3396830. ISSN 1944-3277. PMC 3764934. PMID 24019988.